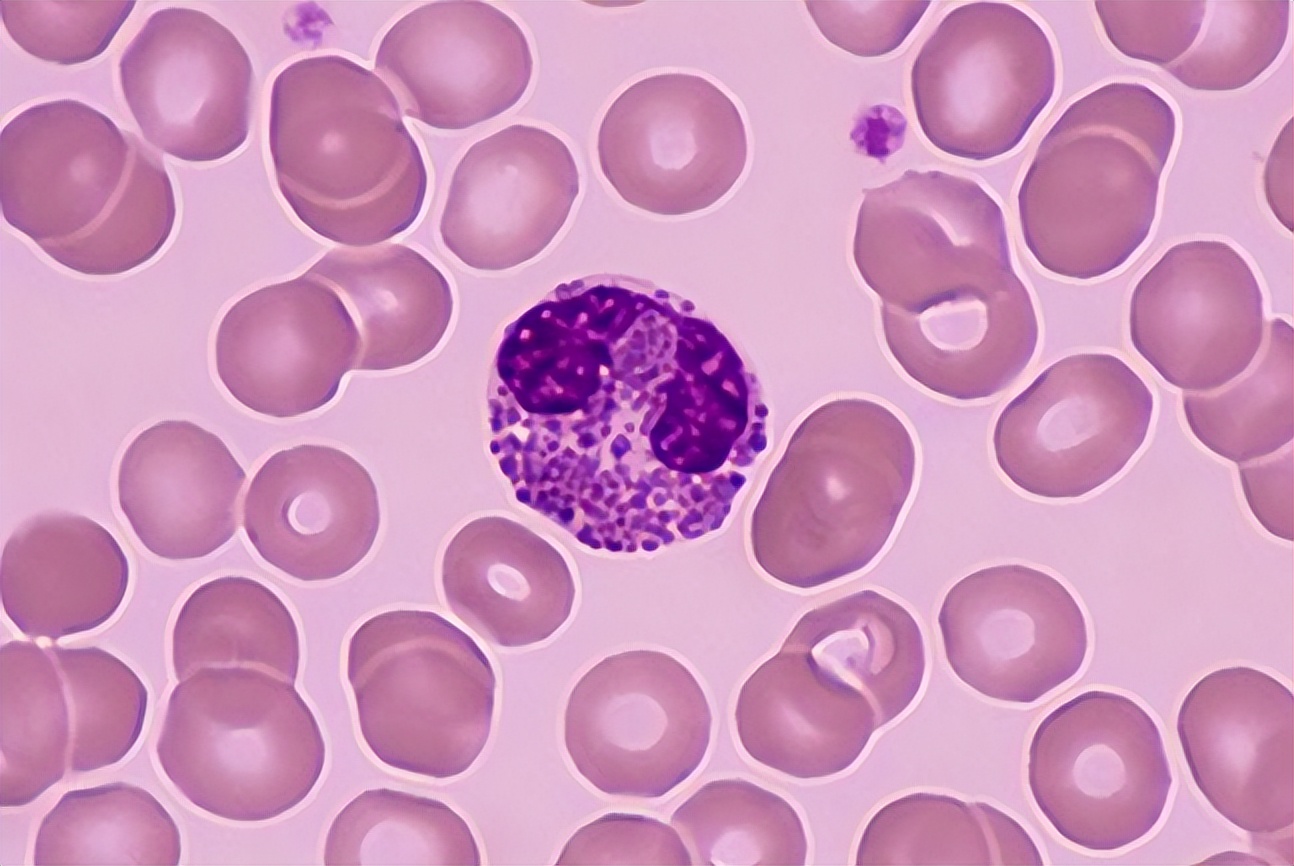
血常规哪些项目异常要警惕,血常规这几项异常一定要引起重视

身体一旦出现问题,会选择去医院检查,而较为常见的常规项目便是血常规检查,可通过观测血液各项指标,判断身体是否存在异常。
虽然血常规比较大众普遍普通,但能及时反映血液健康状况,进一步反馈脏器问题。

关于血常规
【血常规主要看哪些指标?】
血常规检测主要看红细胞以及血红蛋白浓度、白细胞数还有血小板数。 血常规检测也叫全血细胞计数,通过检测患者的血小板数,可以判断患者是否有出血倾向。
成年男性血红蛋白正常值为120-160g/L,成年女性为110-150g/L。白细胞计数成年人为(4-10)×10^9/L,白细胞分类百分数正常值为中性粒细胞杆状核占0%-5%。
分叶核占50%-70%,嗜酸性粒细胞占0.5%-5%,嗜碱性粒细胞为0%-1%,淋巴细胞为20%-40%,单核细胞为3%-8%,血小板计数正常值为(100-300)x10^9/L。

【血常规的临床意义】
血常规的检查是基础的一个化验,一般用来判断患者是否有存在着感染以及感染的类型。血液取材方便、测试快捷,能反映病人的生理、病理状态的基本信息。
是临床疾病诊断的首要检查项目,不仅能为临床提供进一步检查的线索,还能为某些血液病的诊断提供重要依据。
另外也能够观察患者是否有贫血或者是贫血的严重程度,明确患者是否有血液系统的疾病。如果患者出现了白细胞升高,中性粒细胞升高,说明有细菌感染。如果有淋巴细胞升高,说明患有病毒感染。

【血常规是否要空腹?】
血常规检查不需要空腹,血常规检查反应指标,红细胞、白细胞和血小板,会反映急性时相变化。所以血常规检查根据病情需要,随时做监测感染的状态,治疗效果监测,药物效果监测。
所以血常规检查不需要空腹检查,但是像血糖、血脂、肝功能之类的就有严格的要求,因为吃了东西会对结果产生比较大的影响,所以需要空腹。
从检查的前一天晚上10点开始,就不要再进食或者饮水,直到第二天早晨也不要吃早餐,直接去体检中心检查。检查完毕后再享用营养早餐,然后再开始进行剩余的检查项目。

血常规检查中,若这3个指标升高,要引起警惕,别大意
1.嗜碱粒细胞
在血常规中会包括白细胞的检查,嗜碱粒细胞是白细胞的一种,记住,白细胞是很多细胞的总称。除了嗜碱粒细胞之外,还包括中性粒细胞等。
正常情况下,嗜碱粒细胞的含量是很少的,如果体内发现嗜碱粒细胞明显增多,很大情况是因为体内患有了癌症,所以这时就抓紧时间检查身体,要引起重视。
2.血小板
血常规检查中血小板偏高可见于原发性慢性粒细胞疾病、原发性血小板增多症、真性红细胞增多症等疾病。发生急性化脓性感染、大出血、溶血性贫血、肿瘤、外科手术时,也可引起血小板偏高。
如肝胆外科脾切手术等,血小板可聚集起止血作用,血小板偏低易出血,所以发现血小板很低或者低于(20-30)×10^9/L要做复检。

3.红细胞
体内红细胞是用来运输氧气二氧化碳营养物质的主要媒介,身体内各项组织器官细胞皆需要他的存在,属于强有力支撑者。
要想判断红细胞是否异常,我们可以通过观察血红蛋白,如果体内血红蛋白有明显增加,则代表心肺功能能力极差。若血红蛋白数量减少,可能预示着贫血缺血。

血常规检查有哪些注意事项?
1.合理饮食
在做血常规的前一天,三餐应以清淡饮食为主,避免吃过于油腻、高蛋白食物,避免大量饮酒,以免影响检验结果。另外,如果只是进行血常规检查,是不需要特殊禁食的。
而如果需要同时抽血进行生化检查,则需要做检查前一天的晚上八点以后开始禁食。需要禁食12小时,以免食物成分对生化结果造成影响。

2.少喝水
不要大量饮水后化验血常规,因为大量饮水,水分吸收进入血容量,引起血容量增加。血细胞的密度稀释了,容易造成各种血细胞数量减少的假象,对临床结果产生误导作用。
3.衣着
检查那天,最好穿宽松的衣袖,方便静脉抽血时袖子,清洗衣物,防止针孔感染。采血后应伸直前臂,另一只手按压止血棉球至少5分钟。
不能屈肘止血,也不能捻动棉球,以免发生皮下瘀血。如针眼周围有紫红色,应在24小时后进行热敷,为了防止感染,针孔在24小时内不要沾水。

4.按压时间应充分
各人的凝血时间有差异,有的人需要稍长的时间方可凝血。所以当皮肤表层看似未出血就马上停止压迫,可能会因未完全止血。
而使血液渗至皮下造成青淤,因此按压时间长些,才能完全止血。如有出血倾向,更应延长按压时间。

血常规怎么看?
血常规是血液病常见的检测项目,主要是检查白细胞数、白细胞分类、红细胞、血红蛋白数量以及红细胞相关指数,血小板数量及血小板相关指数。
血常规首先要看白细胞数量是否有增多或者减少,观察白细胞分类是否有异常,白细胞升高并且以中性粒细胞升高为主时,提示可能存在感染。

然后看红细胞数量,红细胞压积,红细胞平均体积,红细胞平均血红蛋白量,红细胞平均血红蛋白浓度,红细胞平均体积分布宽度是否正常。
最后看血小板数量是否正常,血小板压积,血小板平均体积,血小板平均体积分布宽度和变异系数是否正常。

如果发生贫血时,可以查看血红蛋白的浓度,正常血红蛋白的浓度是12-16g/dl,发生贫血时一般是低于12g/dl。
血小板的计数对于了解血液的凝固状态有很好的帮助,比如发生脑血栓、脑出血时,血黏稠度增高,血小板也有可能升高。